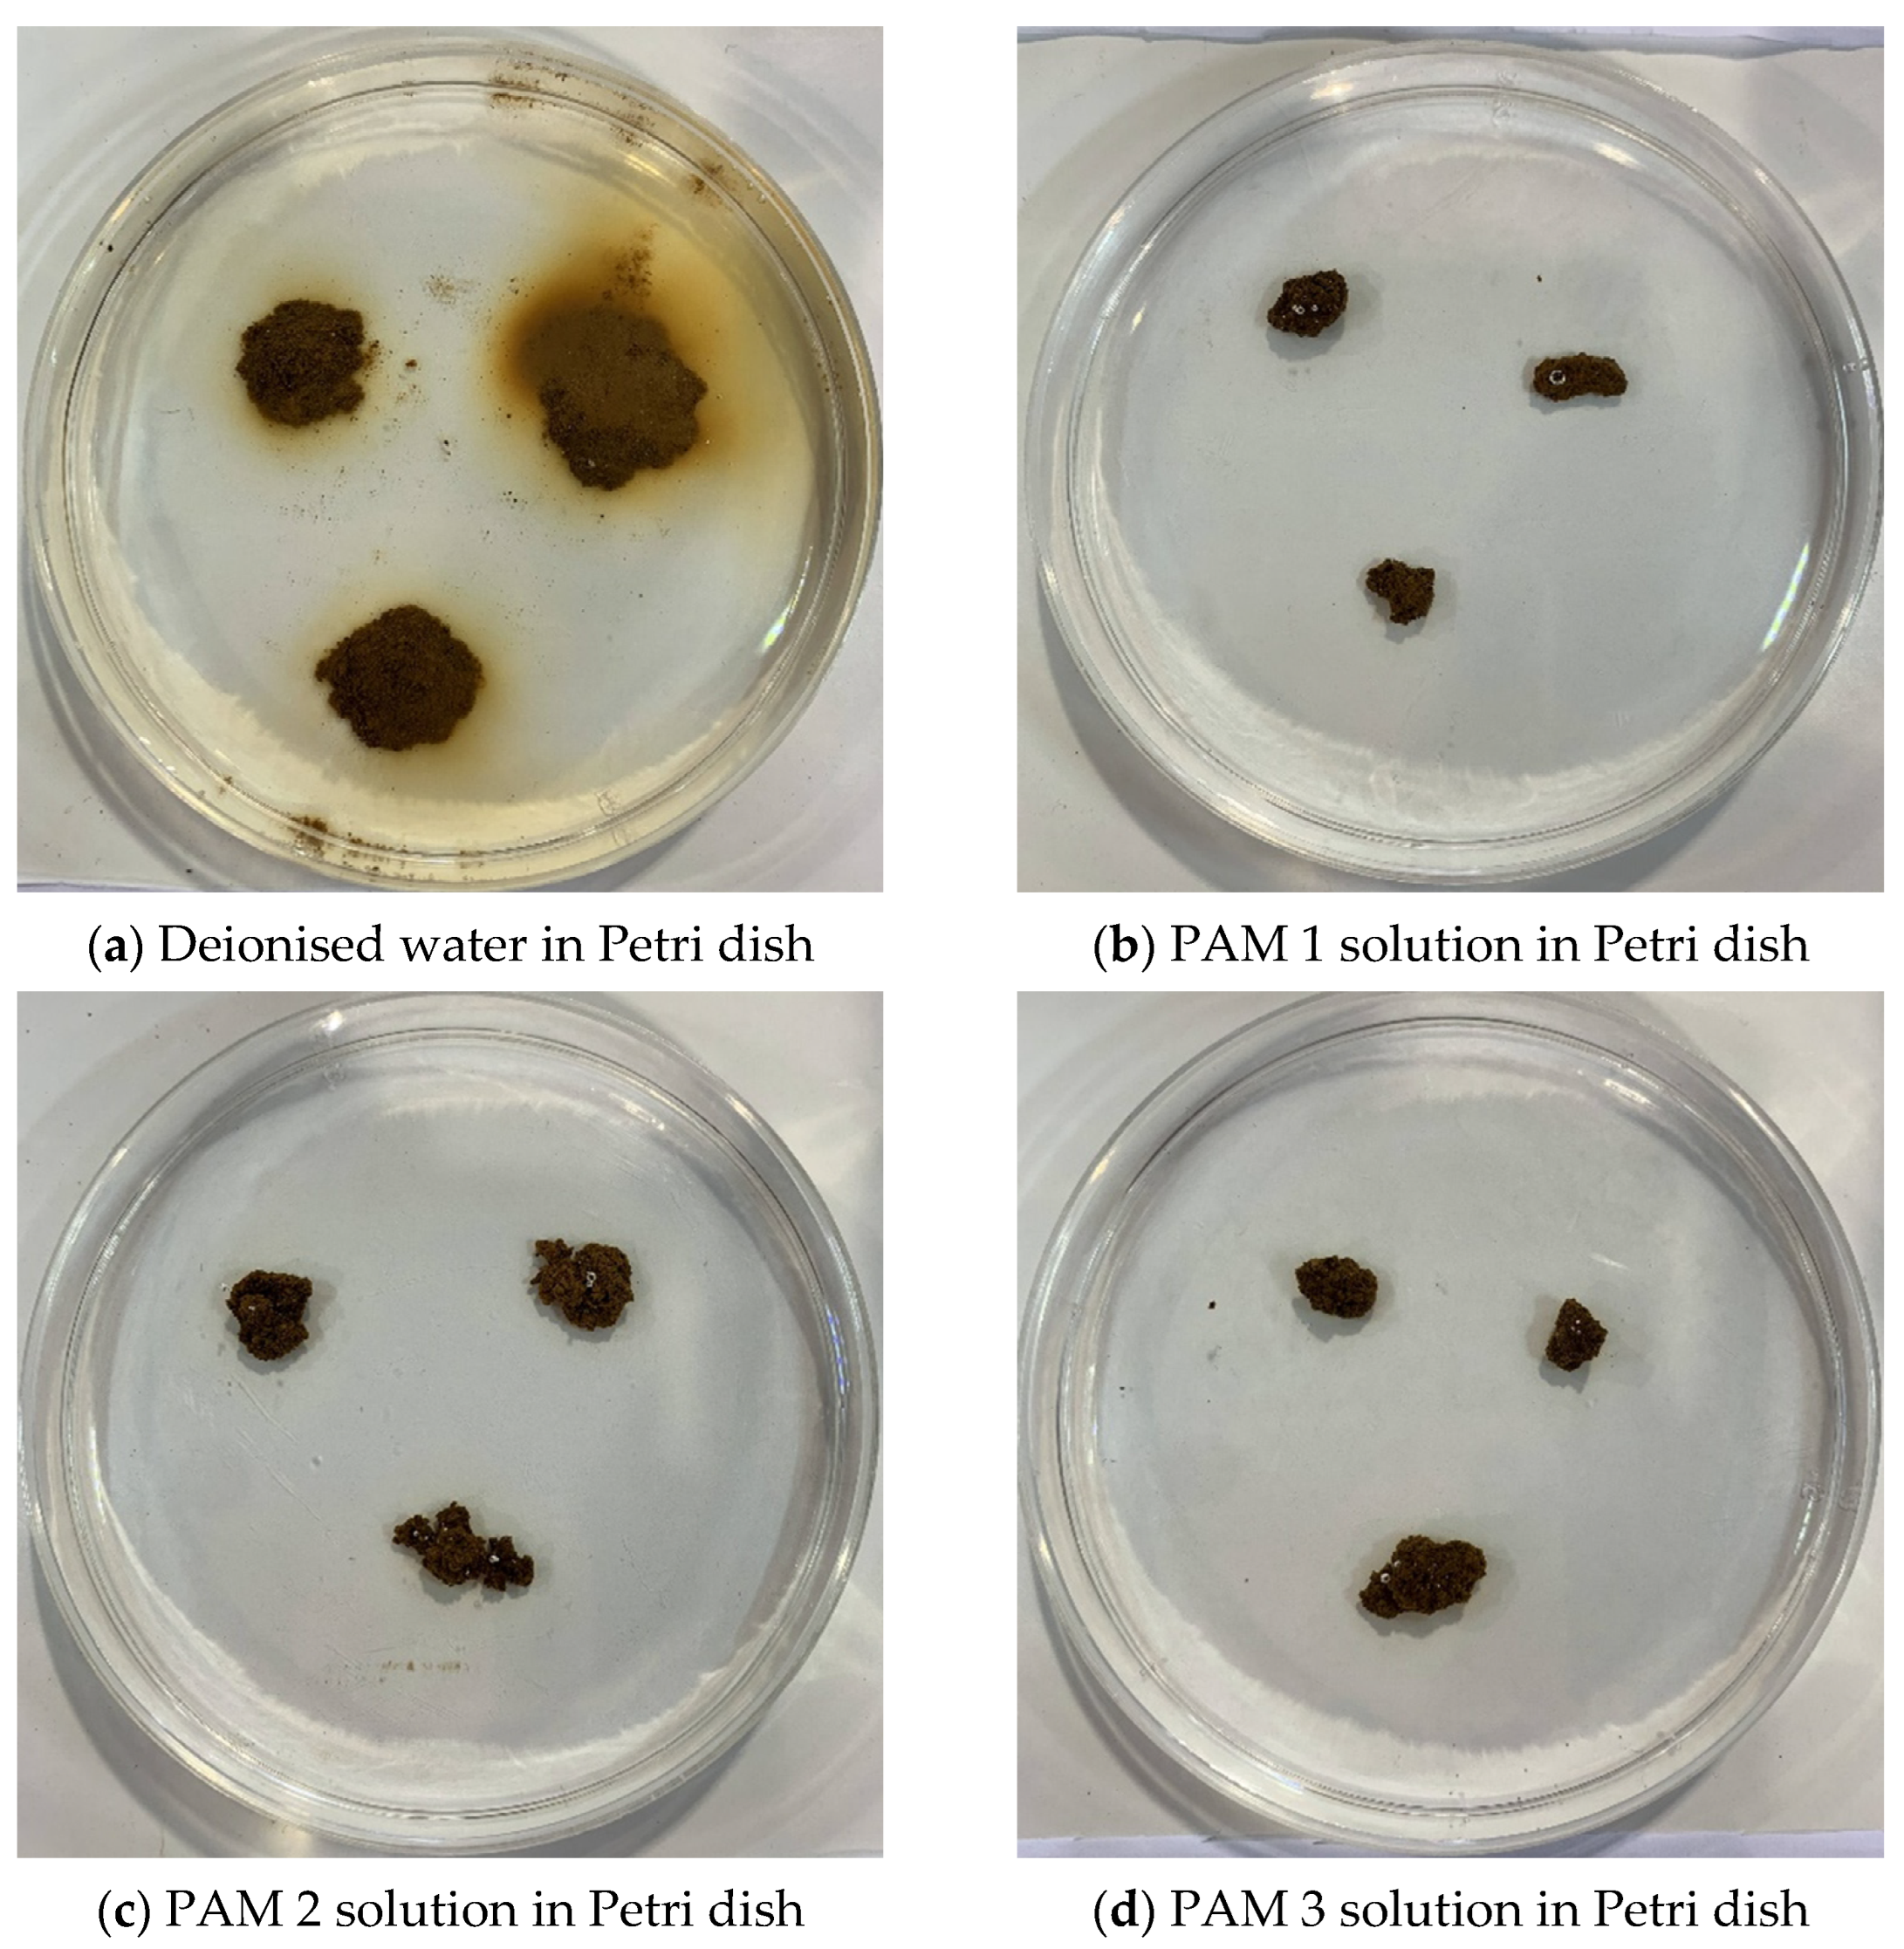
Sustainability 14 13147 g0a1

Targeting Subsoil Constraints in Southern Queensland: Concept Proof of Spraying Polyacrylamide for Subsoil Stabilisation during Tillage
Abstract
1. Introduction
2. Materials and Methods
2.1. Experimental Rationale
2.2. Soil Used
2.3. Polymers
2.4. Polymer Solution Viscosity
2.5. Soil Sodification
2.6. Soil Aggregate Stability
2.7. Clay Dispersion
2.8. Statistical Analysis
3. Results
3.1. Polymer Viscosity Evaluation
3.2. Soil Sodicity Evaluation
3.3. Soil Aggregate Stability upon Immersion
3.4. Soil Aggregate Stability of PAM-Coated Samples upon Immersion
3.5. Spontaneous and Mechanically Dispersed Clay
4. Discussion
4.1. PAM Coating Increased Soil Aggregate Stability
4.2. Effect of PAM on Soil Aggregate Stability Related to its Concentration, Viscosity, Application Rate, Soil Characteristics, and Mechanical Force
4.3. Concept Design, Practical Implications, and Economic Considerations
- Feasibility for spraying: The viscosity of PAM solution is an important parameter in deciding the feasibility of spray and to select the suitable nozzles [59]. Spraying the concentrated and viscous PAM solution can be difficult [53]. At a 3 g L–1 concentration and very low shear rate (s–1), the viscosity ranges between approximately 300 and 2500 mPa∙s, which, for ease of comparison, is within the Society for Automobile Engineers (SAE) 20 to SAE 60 motor oil [60], the latter actually being polymer thickened. An order of magnitude increase in shear rate (s–1) resulted in a reduction in viscosity to between approximately 150 and 450 mPa∙s, equivalent to the SAE 20 to SAE 30 motor oil range. The purpose of this comparison to engine oil is to ensure pressurised flow and spray [61], and by extension we would expect this to be feasible for PAM in solution with water. While the presented results, and consideration of engine oil, suggest it would be feasible to apply PAM via a spray-based mechanism into ripped slots, further work will be needed to determine the surface tension and subsequent effect on spray nozzle spread, as well as droplet size and efficiency of coating [59]. The temperature of the solution should also be considered within the ambient range, and where higher flow rate difficulties are encountered.
- Application concentration: In considering the aggregate stability results, PAM concentrations ≥1.5 g L–1 were recommended. However, the required amount of water and viscosity of PAM solution vary significantly, which further affects the selection of spraying nozzle, pump pressure, and flow rate.
- PAM degradation: Spraying PAM through pressure pumps may affect the structure and viscosity, and the subsequent effect on soil structural stability needs to be evaluated. A high molecular PAM can degrade under light exposure, which generates free radicals leading to chain scission [62]. Ideally, after spraying PAM product into ripped slots, it should not be exposed to sunlight unless another deep ripping is undertaken. Chemical degradation, similar to photolytic degradation, could occur when PAM interacts with free radicals, such as oxygen and dissolved Fe2+. The high molecular weight of PAM makes it less accessible to microbial degradation, and only few microorganisms utilise the amide group as a nitrogen and/or carbon source [63]. The degraded monomer acrylamide is toxic to most microorganisms, but some bacteria and fungi can further degrade it to a final product of ammonium, CO2, and water [64].
- Dual application with gypsum: When gypsum particulate and PAM solution are both applied into the subsoil during tillage, the water from the PAM solution is likely to facilitate the dissolution of gypsum, though it is also dependent on gypsum particle size, temperature, etc. The co-application of gypsum and PAM to sodic soil may be more effective than either application alone in reducing dispersion [65] and improving crop yield [66].
- Economics: In consideration of subsoil treatment between 20 and 80 cm depth and an opening width of 1 cm (PAM-treated zone), one hectare would require 18 kg PAM (over USD 90), at an application rate of 1.0 g kg–1 PAM/soil on the aggregate surface (with an average diameter 5 cm). This is based on PAM not penetrating aggregates [67]. Further, the actual application rate can be varying, which is depending on soil texture and other factors. Considering that greater rates might be required, the use of PAM as a ubiquitous application is not readily economically feasible. However, the application of PAM into subsoil may be economically achieved by using it tactically in stabilising recently established rip lines within dispersive soils only; i.e., only applied where needed, which could be determined using the approaches explained in Roberton et al. [36]. Other cost includes deep ripping, gypsum, operation, water, and pump systems.
5. Conclusions
Author Contributions
Funding
Institutional Review Board Statement
Informed Consent Statement
Data Availability Statement
Acknowledgments
Conflicts of Interest
Appendix A
References
- Dang, Y.P.; Dalal, R.C.; Routley, R.; Schwenke, G.D.; Daniells, I. Subsoil constraints to grain production in the cropping soils of the north-eastern region of Australia: An overview. Aust. J. Exp. Agric. 2006, 46, 19–35. [Google Scholar] [CrossRef]
- Cassidy, N. Effect of Irrigation Water on Heavy Clay Soils at Dalby; Queensland Department of Primary Industries: Brisbane, QLD, Australia, 1971. [Google Scholar]
- Keller, T.; Sandin, M.; Colombi, T.; Horn, R.; Or, D. Historical increase in agricultural machinery weights enhanced soil stress levels and adversely affected soil functioning. Soil Tillage Res. 2019, 194, 104293. [Google Scholar] [CrossRef]
- Antille, D.L.; Bennett, J.M.; Jensen, T.A. Soil compaction and controlled traffic considerations in Australian cotton-farming systems. Crop Pasture Sci. 2016, 67, 1–28. [Google Scholar] [CrossRef]
- Bennett, J.; Woodhouse, N.P.; Keller, T.; Jensen, T.A.; Antille, D.L. Advances in cotton harvesting technology: A review and implications for the John Deere round baler cotton picker. J. Cotton Sci. 2015, 19, 225–249. [Google Scholar]
- McKenzie, D.; McBratney, A. Cotton root growth in a compacted Vertisol (Grey Vertosol). I. Prediction using strength measurements and ‘limiting water ranges’. Soil Res. 2001, 39, 1157–1168. [Google Scholar] [CrossRef]
- Kay, B. Rates of change of soil structure under different cropping systems. In Advances in Soil Science 12; Stewart, B.A., Ed.; Springer: New York, NY, USA, 1990; pp. 1–52. [Google Scholar]
- Blackwell, P.S.; Jayawardane, N.S.; Green, T.W.; Wood, J.T.; Blackwell, J.; Beatty, H.J. Subsoil macropore space of a transitional red-brown earth after either deep tillage, gypsum or both. II. Chemical effects and long term changes. Soil Res. 1991, 29, 141–154. [Google Scholar] [CrossRef]
- Blaikie, S.J.; Kelly, K.B.; Mason, W.K.; Martin, F.M. Productivity of irrigated pastures following paraplowing and gypsum slotting of subsoil exposed by laser landforming dash a short term study. Aust. J. Agric. Res. 1988, 39, 837–845. [Google Scholar] [CrossRef]
- Jayawardane, N.S.; Blackwell, J. The effect of gypsum enriched slots on moisture environment and aeration in an irrigated swelling clay. Aust. J. Soil Res. 1985, 23, 481–492. [Google Scholar] [CrossRef]
- Kelly, K.B. Effects of soil modification and treading on pasture growth and physical properties of an irrigated red-brown earth. Aust. J. Agric. Res. 1985, 36, 799–807. [Google Scholar] [CrossRef]
- McBeath, T.M.; Grant, C.D.; Murray, R.S.; Chittleborough, D.J. Effects of subsoil amendments on soil physical properties, crop response, and soil water quality in a dry year. Soil Res. 2010, 48, 140–149. [Google Scholar] [CrossRef]
- Nuttall, J.G.; Armstrong, R.D.; Connor, D.J. The effect of boron tolerance, deep ripping with gypsum, and water supply on subsoil water extraction of cereals on an alkaline soil. Aust. J. Agric. Res. 2005, 56, 113–122. [Google Scholar] [CrossRef]
- Prathapar, S.A.; Aslam, M.; Kahlown, M.A.; Iqbal, Z.; Qureshi, A.S. Gypsum slotting to ameliorate sodic soils of Pakistan. Irrig. Drain. 2005, 54, 509–517. [Google Scholar] [CrossRef]
- Stockdale, C.R. Irrigated pasture productivity and its variability in the Shepparton region of northern Victoria. Aust. J. Exp. Agric. 1983, 23, 131–139. [Google Scholar] [CrossRef]
- Ekebafe, L.; Ogbeifun, D.; Okieimen, F. Polymer applications in agriculture. Biokemistri 2011, 23, 81–89. [Google Scholar]
- Wallace, A.; Terry, R.E. Handbook of Soil Conditionerssubstances That Enhance the Physical Properties of Soil; Marcel Dekker: New York, NY, USA, 1998. [Google Scholar]
- Levy, G.J.; Warrington, D.N. Polyacrylamide addition to soils: Impacts on soil structure and stability. In Functional Polymers in Food Science; Wiley: Hoboken, NJ, USA, 2015; pp. 9–31. [Google Scholar]
- Mamedov, A.; Wagner, L.; Huang, C.; Norton, L.; Levy, G. Polyacrylamide effects on aggregate and structure stability of soils with different clay mineralogy. Soil Sci. Soc. Am. J. 2010, 74, 1720–1732. [Google Scholar] [CrossRef]
- Al-Abed, N.; Amayreh, J.; Shudifat, E.; Qaqish, L.; El-Mehaisin, G. Polyacrylamide (PAM) effect on irrigation induced soil erosion and infiltration. Arch. Agron. Soil Sci. 2003, 49, 301–308. [Google Scholar] [CrossRef]
- Ben-Hur, M.; Malik, M.; Letey, J.; Mingelgrin, U. Adsorption of polymers on clays as affected by clay charge and structure, polymer properties, and water quality. Soil Sci. 1992, 153, 349–356. [Google Scholar] [CrossRef]
- Letey, J. Adsorption and desorption of polymers on soil. Soil Sci. 1994, 158, 244–248. [Google Scholar] [CrossRef]
- Liu, J.; Song, Z.; Bai, Y.; Chen, Z.; Wei, J.; Wang, Y.; Qian, W. Laboratory Tests on Effectiveness of Environment-Friendly Organic Polymer on Physical Properties of Sand. Int. J. Polym. Sci. 2018, 2018, 5865247. [Google Scholar] [CrossRef]
- Sepaskhah, A.; Shahabizad, V. Effects of water quality and PAM application rate on the control of soil erosion, water infiltration and runoff for different soil textures measured in a rainfall simulator. Biosys. Eng. 2010, 106, 513–520. [Google Scholar] [CrossRef]
- Yang, Q.; Pei, X.; Huang, R. Impact of polymer mixtures on the stabilization and erosion control of silty sand slope. J. Mt. Sci. 2019, 16, 470–485. [Google Scholar] [CrossRef]
- Kebede, B.; Tsunekawa, A.; Haregeweyn, N.; Mamedov, A.I.; Tsubo, M.; Fenta, A.A.; Meshesha, D.T.; Masunaga, T.; Adgo, E.; Abebe, G. Effectiveness of Polyacrylamide in Reducing Runoff and Soil Loss under Consecutive Rainfall Storms. Sustainability 2020, 12, 1597. [Google Scholar] [CrossRef]
- Green, V.S.; Stott, D.; Norton, L.; Graveel, J. Polyacrylamide molecular weight and charge effects on infiltration under simulated rainfall. Soil Sci. Soc. Am. J. 2000, 64, 1786–1791. [Google Scholar] [CrossRef]
- Mamedov, A.; Beckmann, S.; Huang, C.; Levy, G. Aggregate stability as affected by polyacrylamide molecular weight, soil texture, and water quality. Soil Sci. Soc. Am. J. 2007, 71, 1909–1918. [Google Scholar] [CrossRef]
- Mamedov, A.I.; Tsunekawa, A.; Haregeweyn, N.; Tsubo, M.; Fujimaki, H.; Kawai, T.; Kebede, B.; Mulualem, T.; Abebe, G.; Wubet, A. Soil structure stability under different land uses in association with polyacrylamide effects. Sustainability 2021, 13, 1407. [Google Scholar] [CrossRef]
- Dodd, K.; Guppy, C.; Lockwood, P.V.; Rochester, I.J. The effect of sodicity on cotton: Does soil chemistry or soil physical condition have the greater role? Crop Pasture Sci. 2013, 64, 806–815. [Google Scholar] [CrossRef]
- Laird, D.A. Bonding between polyacrylamide and clay mineral surfaces. Soil Sci. 1997, 162, 826–832. [Google Scholar] [CrossRef]
- Green, V.S.; Stott, D. Polyacrylamide: A review of the use, effectiveness, and cost of a soil erosion control amendment. In Proceedings of the 10th International Soil Conservation Organization Meeting, West Lafayette, IN, USA, 23–28 May 1999; pp. 384–389. [Google Scholar]
- Nadler, A.; Perfect, E.; Kay, B.D. Effect of polyacrylamide application on the stability of dry and wet aggregates. Soil Sci. Soc. Am. J. 1996, 60, 555–561. [Google Scholar] [CrossRef]
- Oliver, Y.; Wong, M.; Robertson, M.; Wittwer, K. PAWC determines spatial variability in grain yield and nitrogen requirement by interacting with rainfall on northern WA sandplain. In Proceedings of the 13th Australian Agronomy Conference, Perth, Australia, 10–14 September 2006; pp. 10–14. [Google Scholar]
- Roberton, S.D.; Lobsey, C.R.; Bennett, J.M. A Bayesian approach toward the use of qualitative information to inform on-farm decision making: The example of soil compaction. Geoderma 2021, 382, 114705. [Google Scholar] [CrossRef]
- Roberton, S.D.; Bennett, J.M.; Lobsey, C.R.; Bishop, T.F. Assessing the Sensitivity of Site-Specific Lime and Gypsum Recommendations to Soil Sampling Techniques and Spatial Density of Data Collection in Australian Agriculture: A Pedometric Approach. Agronomy 2020, 10, 1676. [Google Scholar] [CrossRef]
- Filippi, P.; Jones, E.J.; Ginns, B.J.; Whelan, B.M.; Roth, G.W.; Bishop, T.F. Mapping the depth-to-soil pH constraint, and the relationship with cotton and grain yield at the within-field scale. Agronomy 2019, 9, 251. [Google Scholar] [CrossRef]
- Isbell, R. The Australian Soil Classification; CSIRO Publishing: Clayton South, Australia, 2016. [Google Scholar]
- Rayment, G.E.; Lyons, D.J. Soil Chemical Methods: Australasia; CSIRO Publishing: Collingwood, Australia, 2011. [Google Scholar]
- Rengasamy, P.; Marchuk, A. Cation ratio of soil structural stability (CROSS). Soil Res. 2011, 49, 280–285. [Google Scholar] [CrossRef]
- Bennett, J.M.; Marchuk, A.; Marchuk, S. An alternative index to ESP for explanation of dispersion occurring in soils. Soil Res. 2016, 54, 949–957. [Google Scholar] [CrossRef]
- Gee, G.W.; Bauder, J.W. Particle-size analysis. In Methods of Soil Analysis. Part 1. Physical and Mineralogical Methods; Klute, A., Ed.; The American Society of Agronomy, Inc.: Madison, WI, USA, 1986; pp. 383–411. [Google Scholar]
- Dodd, K.; Guppy, C.; Lockwood, P. Overcoming the confounding effects of salinity on sodic soil research. Commun. Soil Sci. Plant Anal. 2010, 41, 2211–2219. [Google Scholar] [CrossRef]
- McMullen, B. SOILpak for Vegetable Growers; NSW Agriculture: Orange, Australia, 2000. [Google Scholar]
- Field, D.J.; McKenzie, D.C.; Koppi, A.J. Development of an improved Vertisol stability test for SOILpak. Soil Res. 1997, 35, 843–852. [Google Scholar] [CrossRef]
- Loveday, J.; Pyle, J.C. Emerson Dispersion Test and Its Relationship to Hydraulic Conductivity; Commonwealth Scientific and Industrial Research Organization: Melbourne, Australia, 1973; pp. 1–7. [Google Scholar]
- Zhu, Y.; Marchuk, A.; Bennett, J.M. Rapid method for assessment of soil structural stability by turbidimeter. Soil Sci. Soc. Am. J. 2016, 80, 1629–1637. [Google Scholar]
- Ewoldt, R.H.; Johnston, M.T.; Caretta, L.M. Experimental challenges of shear rheology: How to avoid bad data. In Complex Fluids in Biological Systems; Springer: New York, NY, USA, 2015; pp. 207–241. [Google Scholar]
- Emerson, W. The slaking of soil crumbs as influenced by clay mineral composition. Soil Res. 1964, 2, 211–217. [Google Scholar] [CrossRef]
- Green, V.S.; Stott, D.E.; Graveel, J.G.; Norton, L.D. Stability analysis of soil aggregates treated with anionic polyacrylamides of different molecular formulations. Soil Sci. 2004, 169, 573–581. [Google Scholar] [CrossRef]
- Sojka, R.E.; Bjorneberg, D.L.; Entry, J.A.; Lentz, R.D.; Orts, W.J. Polyacrylamide in agriculture and environmental land management. Adv. Agron. 2007, 92, 75–162. [Google Scholar]
- Lu, J.; Wu, L.; Letey, J. Effects of soil and water properties on anionic polyacrylamide sorption. Soil Sci. Soc. Am. J. 2002, 66, 578–584. [Google Scholar] [CrossRef]
- Abrol, V.; Shainberg, I.; Lado, M.; Ben-Hur, M. Efficacy of dry granular anionic polyacrylamide (PAM) on infiltration, runoff and erosion. Eur. J. Soil Sci. 2013, 64, 699–705. [Google Scholar] [CrossRef]
- McLaughlin, R.A.; Bartholomew, N. Soil factors influencing suspended sediment flocculation by polyacrylamide. Soil Sci. Soc. Am. J. 2007, 71, 537–544. [Google Scholar] [CrossRef]
- Bennett, J.M.; Marchuk, A.; Marchuk, S.; Raine, S.R. Towards predicting the soil-specific threshold electrolyte concentration of soil as a reduction in saturated hydraulic conductivity: The role of clay net negative charge. Geoderma 2019, 337, 122–131. [Google Scholar] [CrossRef]
- Stojek, Z. The electrical double layer and its structure. In Electroanalytical Methods; Scholz, F., Ed.; Springer: Berlin/Heidelberg, Germany, 2010; pp. 3–9. [Google Scholar]
- Liu, D.; Ren, S.-M.; Yang, P.-L. Influence of PAM to Soil Hydraulic Conductivity and Water Holding Capacity. J. Irrig. Drain. 2006, 25, 56–59. [Google Scholar]
- Sivapalan, S. Benefits of treating a sandy soil with a crosslinked-type polyacrylamide. Aust. J. Exp. Agric. 2006, 46, 579–584. [Google Scholar] [CrossRef]
- Davanlou, A.; Lee, J.D.; Basu, S.; Kumar, R. Effect of viscosity and surface tension on breakup and coalescence of bicomponent sprays. Chem. Eng. Sci. 2015, 131, 243–255. [Google Scholar] [CrossRef]
- McMillan, M.L. Engine oil viscosity classifications-past, present, and future. In The Relationship between Engine Oil Viscosity and Engine Performance; ASTM International: Detroit, MI, USA, 1977. [Google Scholar]
- Bush, S.G. High Viscosity Pump Sprayer Utilizing Fan Spray Nozzle. U.S. Patent 5,639,025, 17 June 1997. [Google Scholar]
- Xiong, B.; Loss, R.D.; Shields, D.; Pawlik, T.; Hochreiter, R.; Zydney, A.L.; Kumar, M. Polyacrylamide degradation and its implications in environmental systems. npj Clean Water 2018, 1, 1–9. [Google Scholar] [CrossRef]
- Wen, Q.; Chen, Z.; Zhao, Y.; Zhang, H.; Feng, Y. Biodegradation of polyacrylamide by bacteria isolated from activated sludge and oil-contaminated soil. J. Hazard. Mater. 2010, 175, 955–959. [Google Scholar] [CrossRef]
- Joshi, S.J.; Abed, R.M. Biodegradation of polyacrylamide and its derivatives. Environ. Process. 2017, 4, 463–476. [Google Scholar] [CrossRef]
- Sivapalan, S. Effect of gypsum and polyacrylamides on water turbidity and infiltration in a sodic soil. Soil Res. 2005, 43, 723–733. [Google Scholar] [CrossRef][Green Version]
- Sivapalan, S. Soybean responds to amelioration of sodic soils using polyacrylamides. Irrig. Aust. 2003, 18, 45–47. [Google Scholar]
- Malik, M.; Letey, J. Adsorption of polyacrylamide and polysaccharide polymers on soil materials. Soil Sci. Soc. Am. J. 1991, 55, 380–383. [Google Scholar] [CrossRef]







| Properties | Dermosol 1 | Vertosol 1 | Kandosol 1 | |
|---|---|---|---|---|
| Depth | cm | 0–30 | 0–30 | 0–30 |
| pH (1:5) | 8.8 | 7.5 | 7.1 | |
| EC 2 (1:5) | dS m–1 | 0.30 | 0.17 | 0.05 |
| SAR 3 | (mmolc L–1)–0.5 | 4.3 | 1.6 | 0.1 |
| CROSS 4 | (mmolc L–1)–0.5 | 4.6 | 1.8 | 0.5 |
| ESP 5 | % | 11.7 | 2.3 | 0.6 |
| EDP 6 | % | 12.5 | 3.7 | 2.3 |
| CEC 7 | 18.6 | 42.3 | 5.0 | |
| Organic carbon | % | 1.6 | 1.0 | 1.6 |
| Soil texture | ||||
| Clay | % | 34 | 60 | 13 |
| Silt | % | 16 | 11 | 5 |
| Sand | % | 50 | 29 | 82 |
| Dry aggregate size | ||||
| >10 mm | % | 16.4 | 9.1 | 9.6 |
| 4–10 mm | % | 14.3 | 21.8 | 11.5 |
| 2–4 mm | % | 12.3 | 26.1 | 5.9 |
| 1–2 mm | % | 11 | 20.3 | 4.8 |
| 0.6–1 mm | % | 13 | 11.8 | 5.1 |
| 250–600 µm | % | 16.4 | 7.6 | 30.3 |
| 150–250 µm | % | 6.9 | 1.8 | 19.1 |
| 75–150 µm | % | 5.3 | 1.0 | 7.1 |
| <75 µm | % | 4.4 | 0.4 | 6.6 |
| dMWD 8 | mm | 3.7 | 3.8 | 2.4 |
| Australian taxonomic class | Red Dermosol | Black Vertosol | Red Kandosol | |
| Location in Australia | North Star, NSW | Dalby, QLD | St. George, QLD |
| Concentration | PAM-1 | PAM-2 | PAM-3 | |||
|---|---|---|---|---|---|---|
| pH | EC | pH | EC | pH | EC | |
| g L−1 | dS m−1 | dS m−1 | dS m−1 | |||
| 0.05 | 6.6 | 0.03 | 6.2 | 0.02 | 6.9 | 0.01 |
| 0.20 | 6.7 | 0.09 | 6.8 | 0.05 | 7.1 | 0.05 |
| 0.40 | 6.9 | 0.18 | 7.0 | 0.07 | 7.6 | 0.09 |
| 0.75 | 7.4 | 0.26 | 7.8 | 0.13 | 7.6 | 0.16 |
| 1.50 | 7.3 | 0.61 | 7.9 | 0.24 | 7.6 | 0.25 |
| 3.00 | 7.2 | 1.32 | 7.7 | 0.38 | 7.6 | 0.51 |
| 6.00 | 7.2 | 2.57 | 7.7 | 0.76 | 7.6 | 0.87 |
| Dermosol | Vertosol | Kandosol | |||||||
|---|---|---|---|---|---|---|---|---|---|
| SAR of Treatment Solution | Final pH | Final EC | ESP | Final pH | Final EC | ESP | Final pH | Final EC | ESP |
| dS m–1 | % | dS m–1 | % | dS m–1 | % | ||||
| 0 | 7.3 | 0.7 | 0.2 | 6.6 | 1.3 | 0.9 | 6.6 | 0.5 | 1.9 |
| 15 | 7.9 | 0.8 | 12.5 | 6.7 | 1.2 | 8.9 | 6.6 | 0.5 | 12.4 |
| 30 | 8.6 | 0.6 | 19.9 | 6.9 | 1.0 | 12.8 | 6.8 | 0.5 | 22.7 |
| 60 | 8.7 | 0.6 | 25.6 | 6.9 | 1.1 | 14.8 | 6.9 | 0.4 | 29.2 |
Publisher’s Note: MDPI stays neutral with regard to jurisdictional claims in published maps and institutional affiliations. |
© 2022 by the authors. Licensee MDPI, Basel, Switzerland. This article is an open access article distributed under the terms and conditions of the Creative Commons Attribution (CC BY) license (https://creativecommons.org/licenses/by/4.0/).
Share and Cite
Zhu, Y.; Ali, A.; Bennett, J.M.; Guppy, C.; McKenzie, D. Targeting Subsoil Constraints in Southern Queensland: Concept Proof of Spraying Polyacrylamide for Subsoil Stabilisation during Tillage. Sustainability 2022, 14, 13147. https://doi.org/10.3390/su142013147
Zhu Y, Ali A, Bennett JM, Guppy C, McKenzie D. Targeting Subsoil Constraints in Southern Queensland: Concept Proof of Spraying Polyacrylamide for Subsoil Stabilisation during Tillage. Sustainability. 2022; 14(20):13147. https://doi.org/10.3390/su142013147
Chicago/Turabian StyleZhu, Yingcan, Aram Ali, John McLean Bennett, Chris Guppy, and David McKenzie. 2022. "Targeting Subsoil Constraints in Southern Queensland: Concept Proof of Spraying Polyacrylamide for Subsoil Stabilisation during Tillage" Sustainability 14, no. 20: 13147. https://doi.org/10.3390/su142013147
APA StyleZhu, Y., Ali, A., Bennett, J. M., Guppy, C., & McKenzie, D. (2022). Targeting Subsoil Constraints in Southern Queensland: Concept Proof of Spraying Polyacrylamide for Subsoil Stabilisation during Tillage. Sustainability, 14(20), 13147. https://doi.org/10.3390/su142013147

